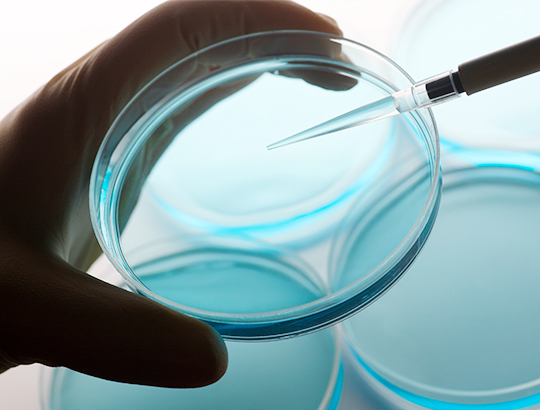

Effective not only outdoors but inside as wellSharp Photocatalytic Technology
Years of experience in semiconductor device development have equipped Sharp with a solid foundation of process technology, while years of experience in MFP toner development and production have made it into an expert in powder pulverization and dispersion.
By integrating these two realms of expertise, Sharp is able to develop a unique photocatalytic material whose effects and safety are objectively attested to through third-party testing.
Updates
- July 27, 2022
- Announcement of Novel coronavirus (Omicron Variant) demonstration
- February 15, 2022
- Announcement of demonstrations: Novel coronavirus, Salmonella typhimurium, Shigella flexneri, and Allergen derived from cedar pollen.
- July 26, 2021
- Announcement of bacteriophage Qβ demonstration
- July 12, 2021
- Announcement of feline enteric coronavirus demonstration
- June 23, 2021
- Announcement of demonstration of novel coronavirus reducing effect
● Some photographs and illustrations on this website are conceptual representations.
MENU